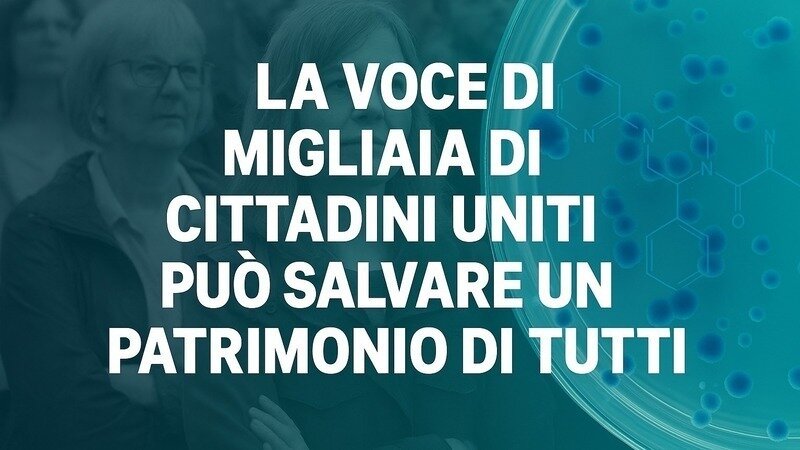

✨ Grazie di cuore agli oltre 6.600 sostenitori! ✨
La vostra vicinanza e il vostro supporto stanno dando forza e visibilità a una battaglia che riguarda non solo Nerviano, ma tutta la comunità scientifica e civile.
Martedì 30, alle 20.45, nella Sala Bergognone all’ex Monastero degli Olivetani, si terrà un Consiglio comunale straordinario e aperto: un appuntamento cruciale per discutere pubblicamente del futuro del polo di ricerca oncologico di Nerviano.
La mobilitazione della comunità è già in corso: si chiede l’apertura urgente di un Tavolo di confronto anche presso il Ministero delle Imprese e del Made in Italy, per trovare soluzioni che evitino i licenziamenti e difendano sia i posti di lavoro sia il patrimonio di competenze che in questi anni ha fatto di Nerviano un simbolo di eccellenza, innovazione e speranza nella lotta contro il cancro.
📢 Martedì sarà un momento decisivo: la comunità nervianese farà sentire la propria voce per difendere questo patrimonio scientifico e umano.
Diretta del Consiglio Comunale : https://www.youtube.com/watch?v=wToF3uvlpuM
🙏 Continuate a condividere e a sostenere questa petizione: insieme possiamo fare la differenza.